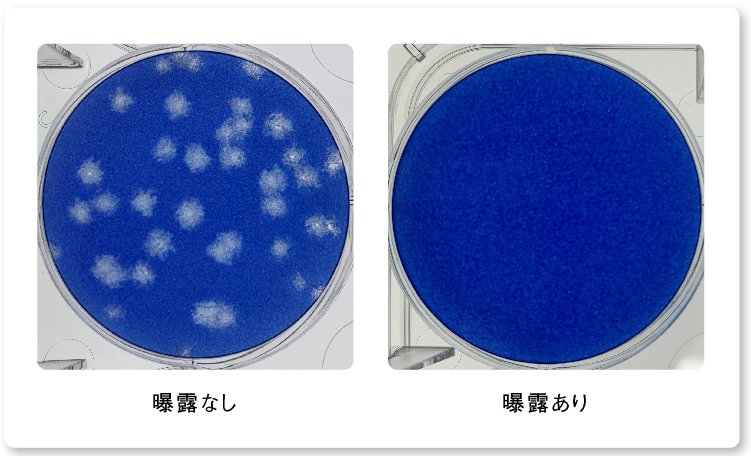
写真：新型コロナウイルス デルタ株の抑制検証のプラーク写真

2022年3月、パナソニックはナノイー(帯電微粒子水)技術について、世界初となる生活空間に近い広さの試験空間(約6畳 /24 m³)で検証。ナノイー(帯電微粒子水)を8時間照射することで、モノに付着した新型コロナウイルスを99%以上抑制※することを実証しました。
※試験は24 m³の試験空間で実施され、実使用における製品の効果を実証したものではありません。
「背景」
2019年に発見され、世界に感染拡大した「新型コロナウイルス感染症」。全世界の累積感染者数は5億人、死者数は600万人を超えました。これまでも新型コロナウイルス(SARS−CoV−2)に対する抑制効果(2020年7月)や、新型コロナウイルス変異株4種に対する抑制効果(2021年11月)についてナノイー(帯電微粒子水)の検証をしてきましたが、小さな試験空間(45L)での実施でした。
※今回の検証は密閉された試験空間での結果であり、実使用空間における効果を検証したものではありません。
「検証結果」
新型コロナウイルス(デルタ株)を99.8%抑制
約6畳(24 m³)という大きな試験空間においても、ナノイー(帯電微粒子水)技術による新型コロナウイルス デルタ株への99.8%以上のウイルス感染価の減少を確認しました。
ナノイー(帯電微粒子水)を8時間曝露した後の
新型コロナウイルス デルタ株の抑制率
プラーク写真
検証方法について
これまでの新型コロナウイルスに対する検証では45Lの小さな空間での実施でしたが、今回は24,000L、約6畳(24 m³ / 2700 mm × 3640 mm × 2450 mm)の実験用チャンバーにナノイー(帯電微粒子水)発生装置を搭載した送風装置を配置し、検証を行いました。
[プレスリリース]
世界初※1 約6畳(24 m³)の試験空間における付着新型コロナウイルスへの「帯電微粒子水(ナノイー)」技術の抑制効果を検証(2022年3月1日)
https://news.panasonic.com/jp/press/jn220301-3